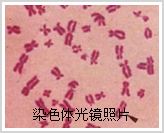

| 导入 |
|
高中《生命科学》第二册第六章第三节,详细介绍了基因工程技术的基本原理,使我们认识到,大肠杆菌质粒是进行重组DNA的鉴定和筛选的常用载体。并且,在高中《生命科学》第二册第57页的广角镜,对质粒进行了更详细的说明。如图所示。

那么,大肠杆菌的质粒与大肠肝菌的生理活动,又有何关系呢?
大肠肝菌(E.coli)是基因工程常用的受体细胞。同时,在基因的结构与功能的研究过程中,进行科学实验时,最常用的一种细胞。
下面,让我们从了解大肠杆菌开始,认识基因表达与调控的基本原理。
大肠杆菌属于原核细胞,它具有原核细胞的典型特征。
1.原核细胞结构
原核细胞结构简单,没有细胞器,也没有细胞核,有一条很大的环状双链DNA分子,称为细菌染色体。但是,在细菌染色体中,DNA分子很少与蛋白质结合,几乎是裸露的。细菌染色体包含了生命活动的所有遗传信息。
2.质粒
许多细菌具有一些小的环状DNA分子,称为质粒。
细菌丢失质粒后,其生长和繁殖,不受影响。
质粒只含有少数基因,如抗生素的抗性基因等。
质粒还能进行自我复制。
3.原核细胞基因的表达
原核细胞基因的mRNA在转录过程还没有完成之前,就开始了翻译过程,合成多肽链。

如图所示,由于原核细胞没有细胞核,转录和翻译过程在时间和空间上没有严格的界限和特定的区域。
|
| 二、原核生物的基因 |
|
下面让我们来了解一下原核生物的基因有哪些特点。
1.原核细胞的基因组

如图所示,原核细胞中,一个mRNA分子可以包含多个基因的转录物,转录出多个功能相关的蛋白质,这些蛋白质共同完成某种生理过程。
因此,在原核细胞的基因组中,往往相关的基因聚集、串连在一起,形成一个基因族群。
同一族群的基因,在功能上是相关的。它们共同表达,共同调控,构成表达和调控的一个单元。这种单元称为操纵子。
2.操纵子
如上图所示,操纵子是原核生物基因结构、表达和调控的基本形式。
一个操纵子,包括一个调控区域和一个以上的结构基因。调控区域一般包含启动子和操纵基因。结构基因编码多肽链。
结构基因的表达受操纵基因的控制,而操纵基因又受调控因子的控制,调控因子是由调控基因编码的。通过操纵基因与调控因子的相互作用,严格控制操纵子的转录活性和基因表达,最终控制细胞内各种蛋白质的数量和决定细菌细胞内各种代谢的活性水平。
在操纵子中,研究得最清楚的就是大肠肝菌的乳糖操纵子。
以乳糖操纵子为例说明。
1.现象
首先,让我们先了解一种现象。

乳糖是牛奶中的一种营养成分。如图所示,如果大肠杆菌生长在没有乳糖的条件下,细胞中只含有几个分子的β半乳糖苷酶。当乳糖存在时,在几分钟内,就在细胞中出现β半乳糖苷酶的活性,很快就能达到几千个分子的β半乳糖苷酶。如果一旦把乳糖去除掉,β半乳糖苷酶的合成就迅速停止。
在这个过程中,环境条件中的乳糖,是如何诱导β半乳糖苷酶的表达与调控的呢? |
| 三、原核生物基因的表达与调控 |
|
2.乳糖操纵子结构组成
原来,大肠杆菌中,存在控制乳糖分解代谢的基因族群,被称为乳糖操纵子。
(1)结构基因


如图所示,乳糖操纵子有3个结构基因组成,分别为lacZ,lacY,lacA,它们的DNA序列连在一起,构成一个共同转录的调控单位。
这3个结构基因分别是:
i.lacZ:编码β半乳糖苷酶。β半乳糖苷酶能分解乳糖,产生半乳糖和葡萄糖。
ii.lacY:编码透性酶。透性酶能把乳糖转运到细胞内。
iii.lacA:编码β半乳糖苷乙酰转移酶,它催化乙酰辅酶A的乙酰基转移到β半乳糖苷上,参与乳糖的代谢过程。
(2)操纵基因和启动子

如图所示,在这3个结构基因的上游还有一些起调控作用的DNA序列,是RNA聚合酶、阻遏蛋白和正向调控因子的结合部位,包括操纵基因和启动子。
|
| 三、原核生物基因的表达与调控 |
|
3.调控基因

如图所示,在乳糖操纵子的上游还有一个lacI基因,是乳糖操纵子的调控基因,调控基因编码阻遏蛋白。调控基因是一个独立的转录单位,有自己的结构基因和调控区域。
阻遏蛋白是操纵子的调控因子,它的活性受到乳糖的控制。在没有乳糖诱导时,阻遏蛋白结合在乳糖操纵子的操纵基因上。当存在乳糖时,乳糖就和阻遏蛋白相结合,使阻遏蛋白不能与操纵基因结合。当阻遏蛋白离开操纵基因后,操纵子的结构基因就可以进行转录。
因此,在乳糖存在的条件下,β半乳糖苷酶基因、透性酶基因和半乳糖苷乙酰转移酶基因,就能进行转录和翻译,从而使操纵子的结构基因得以表达,乳糖代谢过程顺利进行。
4.乳糖操纵子的功能

如图所示,乳糖操纵子是一种诱导酶系统。当存在葡萄糖时,大肠杆菌优先利用葡萄糖。此时,乳糖分解代谢有关的乳糖操纵子被关闭,该操纵子内3个酶的水平非常低。当大肠杆菌没有其他碳源,只有乳糖可利用时,乳糖操纵子就活动起来,操纵子开始进入转录状态,产生mRNA,最后翻译产生3种酶。
了解清楚了基因表达和调控的基本规律,对我们能有效控制基因表达,应用于医学研究和治疗,有非常重要的意义。
但是,毕竟原核生物的基因结构、表达与调控机制相对比较简单。而真核生物基因的结构、表达与调控机制更加复杂。
|
| 四、真核生物的染色质与染色体 |
|
首先,让我们来了解真核生物中遗传物质的结构形式,即真核生物的染色质与染色体。
真核生物的染色质与染色体由DNA和组蛋白、非组蛋白组成。
1.染色质
在细胞核中,真核细胞的遗传物质是以染色质的形式存在的。
根据结构与功能的不同,染色质分成常染色质和异染色质两种类型。

如图所示,左侧为洋葱根尖细胞的光镜照片,右侧为细胞核的电镜照片。
(1)常染色质
常染色质是指细胞核中,染色质纤维折叠压缩的程度比较低,处于伸展状态,用碱性染料染色时,着色浅的那些染色质。
(2)异染色质
是指间期核中,染色质纤维折叠压缩程度高,处于聚缩状态,用碱性染料染色时着色深的那些染色质。
2.染色体
细胞在进行有丝分裂时,染色质浓缩形成染色体。因此,染色体是细胞在有丝分裂时,遗传物质存在的特定形式。
如图所示,分别是细胞的有丝分裂光镜照片、染色体光镜照片、染色体电镜照片、染色体结构模式图。
看来,染色质和染色体的化学本质是相同的,它们的结构也有许多相同点。
下面,就让我们认识染色质与染色体的结构。 |
| 四、真核生物的染色质与染色体 |
|
3.染色质与染色体的结构
(1)核小体

如图所示,核小体是染色质最基本的基本单位。
每个核小体单位包括:一段200碱基对左右的DNA双螺旋、一个4种组蛋白组成的八聚体,一个组蛋白H1分子。其中,核小体的核心是组蛋白八聚体,DNA双螺旋盘绕八聚体,组蛋白H1结合在DNA片段的两端。
(2)螺线管

如图所示,核小体之间有DNA相连,所以,核小体就像一串很长很长的珍珠,核小体的串珠结构再螺旋盘绕,形成螺线管,而且每一圈有6个核小体。
(3)超螺线管
如图所示,超螺线管就像一根很粗的绳子,是经过多次拧结形成的。由核小体螺旋盘绕形成的螺线管,再进一步螺旋盘绕,形成超螺线管。当然,这种超螺线管的口径比起螺线管的口径大多了,因此像一根很长圆筒。
(4)染色单体
在细胞进行有丝分裂时,染色质浓缩形成染色体,并且在有丝分裂后期,姊妹染色体分开,成为染色单体。
如图所示,在电镜下观察到的染色体,就是超螺线管进一步螺旋折叠形成的。
|